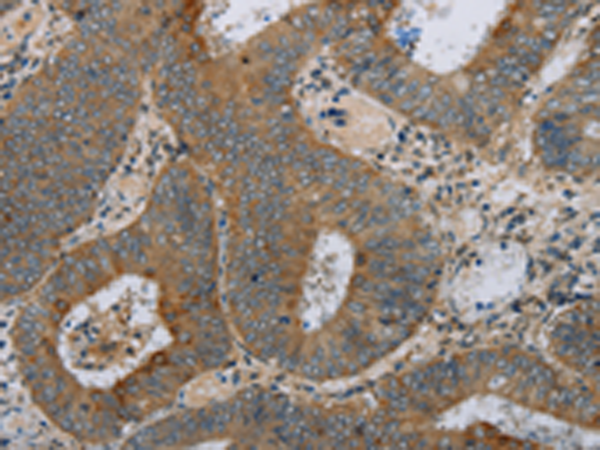
一抗

中文名稱: 兔抗HSD17B14多克隆抗體
別 名: DHRS10; SDR47C1; retSDR3
抗 原: HSD17B14
標 記 物: Unconjugate
克隆類型: rabbit polyclonal
技術規格
|
Background: |
17-beta-hydroxysteroid dehydrogenases, such as HSD17B14, are primarily involved in metabolism of steroids at the C17 position and also of other substrates, such as fatty acids, prostaglandins, and xenobiotics. |
|
Applications: |
ELISA, WB, IHC |
|
Name of antibody: |
HSD17B14 |
|
Immunogen: |
Fusion protein of human HSD17B14 |
|
Full name: |
hydroxysteroid (17-beta) dehydrogenase 14 |
|
Synonyms: |
DHRS10; SDR47C1; retSDR3 |
|
SwissProt: |
Q9BPX1 |
|
ELISA Recommended dilution: |
1000-2000 |
|
IHC positive control: |
Human colon cancer and human liver cancer |
|
IHC Recommend dilution: |
50-200 |
|
WB Predicted band size: |
28 kDa |
|
WB Positive control: |
Mouse kidney tissue |
|
WB Recommended dilution: |
200-1000 |




 購物車
購物車 幫助
幫助
 021-54845833/15800441009
021-54845833/15800441009